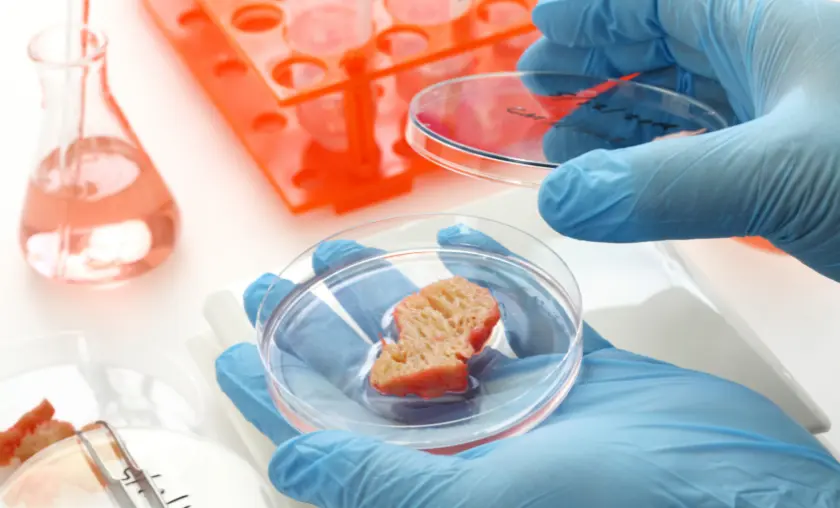
Aspects of Organic Foods with Conventionally Grown Counterparts - TheCompletePortal

Today where conscious consumerism is gaining momentum, this exploration delves into the essence of Organic Foods & agriculture, its impact on both human health and the planet, and the factors that guide our choices. This article sheds light on the rich tapestry of organic offerings and how they align with a holistic approach to wellness, from pesticide-free fruits and vegetables to pasture-raised meats.
By delving into the nuances of organic farming, you’ll uncover insights into how these choices can positively affect both our bodies and the ecosystems we rely upon. Prepare to embark on a journey that navigates the world of organic foods, inviting you to savor the flavors of conscientious eating.
Organic Foods
Organic Farming
Organic farming embodies a commitment to cultivating food naturally, free from synthetic pesticides, genetically modified organisms (GMOs), and chemical fertilizers. This agricultural approach prioritizes sustainability, biodiversity, and soil health, emphasizing the use of natural methods like composting, crop rotation, and biological pest control. Organic practices extend beyond the field to animal husbandry, advocating for humane treatment and access to open spaces for livestock. Consuming organic products is believed to reduce exposure to potentially harmful chemicals and promote environmental conservation.
Methods of Organic Farming:
While organic farming often aligns with healthier practices for both consumers and the planet, it’s important to note that organic doesn’t always equate to superior nutrition, as various factors beyond its production methods influence food’s healthfulness.
Benefits of Organic Foods
Benefits of Organic Foods: Nutritional Value
Organic foods offer distinct benefits, with their nutritional value being notable. Studies suggest that organic produce often contains higher levels of certain nutrients, such as antioxidants and vitamins. These foods are cultivated in soil rich in organic matter, which can result in increased nutrient content. Additionally, organic farming practices prioritize healthy soil and biodiversity, which may contribute to the production of more nutrient-dense crops.
Benefits of Organic Farming:
While the differences in nutritional content can vary and depend on several factors, including crop type and growing conditions, choosing organic foods may offer an avenue to enhance nutrient intake and support overall health.
Reduced Chemical Exposure
Reduced Chemical Exposure: The Pesticide Factor
Reducing chemical exposure is a significant advantage of consuming organic foods, particularly when considering the pesticide factor. Organic farming prohibits the use of synthetic pesticides, which are commonly applied in conventional agriculture to control pests and diseases.
Choosing organic foods can help mitigate potential health risks associated with pesticide residues found on conventionally grown produce. By opting for organic options, individuals can minimize their exposure to these chemical substances, supporting a healthier lifestyle and fostering a safer environment for both consumers and agricultural communities.
Organic Farming Minimizes Chemical Residues

Organic farming takes a proactive approach to minimizing chemical residues in food by adhering to strict guidelines that prohibit the use of synthetic pesticides, herbicides, and genetically modified organisms (GMOs).
This commitment reduces the risk of chemical residues on produce and in the environment. Organic practices prioritize natural methods such as composting, crop rotation, and biological pest control to manage pests and diseases without reliance on chemicals.
Environmental Impact
Environmental Impact: Sustainability at Play
The environmental impact of organic farming reflects a commitment to sustainability. Organic practices prioritize soil health, biodiversity, and reduced chemical usage, minimizing negative effects on ecosystems and water quality. By avoiding synthetic pesticides and promoting natural methods, organic farming helps maintain ecological balance and supports pollinators like bees and butterflies.
Additionally, organic livestock management focuses on animal welfare, with outdoor access and natural diets, contributing to more humane and sustainable practices. Organic foods benefit personal health and foster a healthier planet by supporting agricultural methods that prioritize long-term environmental stewardship.
Organic Farming Supports Ecosystem Health

Organic farming plays a crucial role in supporting ecosystem health through its holistic approach to agriculture. Organic farms create environments that encourage biodiversity and balance within ecosystems by avoiding synthetic pesticides and prioritizing natural pest control methods.
Healthy soil management practices, such as composting and cover cropping, enhance soil structure and nutrient retention, benefiting soil microbes and plant life. This approach supports the overall health of the land, waterways, and wildlife surrounding organic farms.
Organic Certification
Organic Certification: Quality Assurance
Organic certification serves as a hallmark of quality assurance in the realm of food production. Organic farmers and producers undergo rigorous evaluations to ensure that their practices align with established organic standards. These standards encompass everything from soil management and pest control to animal welfare and processing methods. Third-party certifying bodies assess and verify that the entire production chain adheres to these stringent guidelines, from farm to table.
- Prohibition of Synthetic Chemicals: Organic foods cannot be produced using synthetic pesticides, herbicides, or genetically modified organisms (GMOs), ensuring minimal chemical exposure.
- Soil Health: Organic farming practices prioritize healthy soil through methods like composting, crop rotation, and cover cropping, fostering soil fertility and sustainability.
- Animal Welfare: Organic livestock must have access to the outdoors and be provided with natural diets, clean living conditions, and humane treatment.
- Non-GMO: Organic foods must be free from genetically modified ingredients, maintaining the integrity of the natural genetic makeup of crops and livestock.
- Third-Party Certification: Organic products are subject to independent third-party certification, confirming that they meet established organic standards from farm to processing and distribution.
This certification not only provides consumers with confidence in the authenticity of organic products but also upholds the integrity of the organic industry by promoting transparency, accountability, and ethical practices throughout the food supply chain.
Organic vs Conventional
Organic vs. Conventional: Weighing the Differences
The choice between organic and conventional foods involves weighing distinct differences in production methods and potential impacts. Organic farming prioritizes sustainable practices, avoiding synthetic pesticides and emphasizing soil health and biodiversity. Conventional farming, on the other hand, utilizes synthetic chemicals to manage pests and enhance yields.
While organic foods often contain fewer pesticide residues and may have higher nutrient content, they can be more expensive due to the labor-intensive practices involved. Conventional foods may offer affordability and wider availability but might come with concerns about chemical residues and their potential environmental effects.
Aspects of Organic Foods with Conventionally Grown Counterparts
Organic foods and their conventionally grown counterparts differ in several aspects that reflect distinct agricultural practices. Organic foods are cultivated without synthetic pesticides, GMOs, or artificial fertilizers, prioritizing natural pest control and soil fertility methods. Conventional farming, on the other hand, employs synthetic chemicals to enhance yields and combat pests.
While organic foods may contain fewer pesticide residues and potentially offer higher nutrient content, conventional foods might be more readily available and less expensive due to large-scale production. It’s important to note that both options have pros and cons, allowing consumers to choose based on health concerns, environmental impact, and personal preferences.
Cost Considerations
Cost Considerations: Is Organic Worth It?
Cost considerations play a significant role in the decision to choose organic foods. Organic foods are often priced higher than their conventionally grown counterparts due to the labor-intensive and sustainable practices involved in their production. While some argue that the added expense reflects the benefits of reduced pesticide exposure and potential nutritional advantages, others may find it challenging to fit organic options within their budgets.
Factors Surrounding Organic Food Purchases:
It’s essential for individuals to weigh the potential health and environmental benefits against their financial constraints. Ultimately, the decision to invest in organic foods depends on individual values, health considerations, and financial circumstances.
The Future of Organics
The Future of Organics: Trends and Challenges
The future of organics presents both promising trends and enduring challenges. The growing consumer demand for sustainable, health-conscious options continues to fuel the expansion of organic markets. As technology advances, innovative farming practices may enhance yields and address some challenges of organic production. However, challenges persist, including the affordability of organic foods for a broader population and the need for sustainable solutions to address global food security. Balancing the goals of accessibility, environmental stewardship, and profitability remains a complex task.
The future of organics will likely involve continued dialogue on optimizing practices, fostering collaboration between conventional and organic approaches, and leveraging technology’s potential to meet evolving demands for healthier and more sustainable food systems.
Conclusion
In the field of food, organic food is a testimony to a conscious and harmonious relationship with the earth. This exploration of organically grown products and ingredients reveals a world where food is grown with respect for health and the environment. From farm to table, every organic choice is a step toward reduced pesticide exposure and sustainable practices.
As we consider the benefits of organic food, we recognize the importance of supporting local farmers and preserving the integrity of the ecosystems that feed us. Amidst modern agriculture’s complexities, organic food reminds us of the timeless wisdom of working in harmony with nature.
FAQ’s
Why Choose Organic Foods?
Choosing organic foods supports a more environmentally friendly and sustainable agricultural system. Organic farming methods promote soil health, reduce chemical exposure, and often result in higher nutrient content in the produce.
Are Organic Foods More Nutritious Than Conventionally Grown Foods?
Organic foods may have higher nutrient content due to the healthier soil conditions in which they are grown. However, the nutritional difference between organic and conventional foods can vary based on factors like the type of crop and farming practices.
Are All Organic Foods Non-GMO?
Yes, organic foods are non-GMO by definition. They are produced without the use of genetically modified organisms (GMOs), which are common in some conventional farming practices.
Is Buying Organic Foods More Expensive?
Organic foods can be more expensive due to the labor-intensive and environmentally conscious practices involved in their production. However, prices vary based on location and availability.
How Can I Verify if a Product is Truly Organic?
Look for certified organic labels from reputable certification organizations like the USDA Organic label in the United States. These labels indicate that the product meets specific organic farming standards.
To Read More Similar Articles, Click Here.
Thanks for Visiting Our Website. If You Appreciate Our Work, Kindly Show Us Some Support in Our Comments Section 🙂

